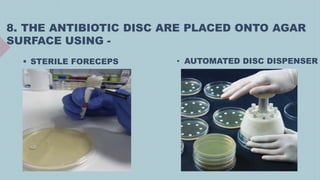
8. THE ANTIBIOTIC DISC ARE PLACED ONTO AGAR
SURFACE USING -
 STERILE FORECEPS • AUTOMATED DISC DISPENSER

This document discusses drug susceptibility testing, which determines if microbes like bacteria or fungi can be inhibited by antimicrobial drugs. There are two main types of testing - qualitative for less serious infections, and quantitative for serious infections. The Kirby-Bauer disk diffusion method is commonly used, involving placing disks with antibiotics on agar plated with a test organism. The size of the inhibition zone is measured to determine resistance or susceptibility. Factors like incubation time and temperature affect results. Minimum inhibitory concentration methods like broth dilution are also used but are more complex. Computer programs help analyze and track susceptibility data.